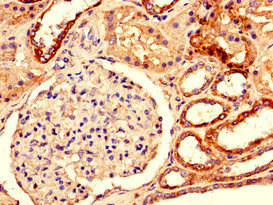

DUSP3 Antibody
-
中文名稱:DUSP3兔多克隆抗體
-
貨號:CSB-PA007255LA01HU
-
規格:¥440
-
圖片:
-
其他:
產品詳情
-
產品名稱:Rabbit anti-Homo sapiens (Human) DUSP3 Polyclonal antibody
-
Uniprot No.:
-
基因名:
-
別名:Dual specificity phosphatase 3 antibody; Dual specificity protein phosphatase 3 antibody; Dual specificity protein phosphatase VHR antibody; DUS3_HUMAN antibody; DUSP3 antibody; Serine/threonine specific protein phosphatase antibody; Vaccinia H1-related phosphatase antibody; Vaccinia virus phosphatase VH1 related antibody; VHR antibody
-
宿主:Rabbit
-
反應種屬:Human
-
免疫原:Recombinant Human Dual specificity protein phosphatase 3 protein (14-96AA)
-
免疫原種屬:Homo sapiens (Human)
-
標記方式:Non-conjugated
本頁面中的產品,DUSP3 Antibody (CSB-PA007255LA01HU),的標記方式是Non-conjugated。對于DUSP3 Antibody,我們還提供其他標記。見下表:
-
克隆類型:Polyclonal
-
抗體亞型:IgG
-
純化方式:>95%, Protein G purified
-
濃度:It differs from different batches. Please contact us to confirm it.
-
保存緩沖液:Preservative: 0.03% Proclin 300
Constituents: 50% Glycerol, 0.01M PBS, PH 7.4 -
產品提供形式:Liquid
-
應用范圍:ELISA, IHC
-
推薦稀釋比:
Application Recommended Dilution IHC 1:20-1:200 -
Protocols:
-
儲存條件:Upon receipt, store at -20°C or -80°C. Avoid repeated freeze.
-
貨期:Basically, we can dispatch the products out in 1-3 working days after receiving your orders. Delivery time maybe differs from different purchasing way or location, please kindly consult your local distributors for specific delivery time.
-
用途:For Research Use Only. Not for use in diagnostic or therapeutic procedures.
相關產品
靶點詳情
-
功能:Shows activity both for tyrosine-protein phosphate and serine-protein phosphate, but displays a strong preference toward phosphotyrosines. Specifically dephosphorylates and inactivates ERK1 and ERK2.
-
基因功能參考文獻:
- Nuclear HSP70 leads to enhancement of vaccinia H1-related phosphatase (VHR) activity via protein-protein interaction rather than its molecular chaperone activity, thereby suppressing excessive ERK activation. Downregulation of either VRK3 or HSP70 rendered cells vulnerable to glutamate-induced apoptosis. PMID: 27941812
- Data indicated that regulating non-receptor tyrosine kinase FAK and cell migration is a newly revealed function of VHR/DUSP3. PMID: 28759036
- The loss of DUSP3 activity markedly increases gamma radiation-induced DNA strand breaks, suggesting a potential novel role for DUSP3 in DNA repair. PMID: 28389334
- In PTP1B and VHR, two new allosteric clusters were identified in each enzyme. PMID: 28625849
- In the phosphatase-silenced cells, the normal bipolar spindle structure was restored by chemical inhibition of Erk1/2 and ectopic overexpression of Dusp3. We propose that at M phase Dusp3 keeps Erk1/2 activity in check to facilitate normal mitosis. PMID: 27423135
- Data suggest levels of gene expression of both DUSP3 (dual specificity phosphatase 3) and PSME3 (proteasome activator subunit 3) are associated with susceptibility to Staphylococcus aureus infection/sepsis in humans and in mouse disease model. PMID: 24901344
- Our results demonstrate that DUSP3 plays a key and nonredundant role as a regulator of innate immune responses PMID: 25876765
- VHR can dimerize inside cells, and that VHR catalytic activity is reduced upon dimerization. PMID: 24798147
- DUSP3 is a pro-angiogenic atypical dual-specificity phosphatase. PMID: 24886454
- DUSP3 interacting partners are nucleolar proteins involved in processes related to DNA repair and senescence. PMID: 24245651
- we report the first successful site-specific incorporation of sulfotyrisine into VHR through the use of expanding genetic code PMID: 23918168
- Proteins containing the class II motifs are efficient VHR substrates in vitro, suggesting that VHR may act on a novel class of yet unidentified Tyr(P) proteins in vivo. PMID: 23322772
- Enteric commensal bacteria induce extracellular signal-regulated kinase pathway signaling via formyl peptide receptor-dependent redox modulation of dual specific phosphatase 3 PMID: 21921027
- VHR expression enhances the signaling of ErbB receptors and may be involved in NSCLC pathogenesis. PMID: 21262974
- VHR, a Vaccinia virus VH1-related dual-specific protein phosphatase, is phosphorylated at Y138 by ZAP-70. PMID: 12447358
- VHR is required for cell-cycle progression as it modulates MAP kinase activation in a cell-cycle phase-dependent manner. PMID: 16604064
- deregulated expression of BRCA1-IRIS is likely to reduce dependence on normal physiological growth stimuli PMID: 17278098
- Small dual-specificity phosphatase VHR selectively dephosphorylates tyrosine-phosphorylated interferon-alpha- and beta-activated transcription factor STAT5, leading to the subsequent inhibition of STAT5 function. PMID: 17785772
- Results highlight the importance of a high intracellular Zn(2+) content and the VHR/ZAP-70/ERK1,2-associated pathways in the modulation of LNCaP prostate cancer cell growth. PMID: 18311544
- VHR can be considered as a new marker for cancer progression in cervix carcinoma and potential new target for anticancer therapy PMID: 18505570
- VHR has a direct role in the inhibition of JNK-dependent apoptosis in LNCaP cells and may therefore have a role in prostate cancer progression. PMID: 19010898
顯示更多
收起更多
-
亞細胞定位:Nucleus.
-
蛋白家族:Protein-tyrosine phosphatase family, Non-receptor class dual specificity subfamily
-
數據庫鏈接:
Most popular with customers
-
-
YWHAB Recombinant Monoclonal Antibody
Applications: ELISA, WB, IHC, IF, FC
Species Reactivity: Human, Mouse, Rat
-
Phospho-YAP1 (S127) Recombinant Monoclonal Antibody
Applications: ELISA, WB, IHC
Species Reactivity: Human
-
-
-
-
-